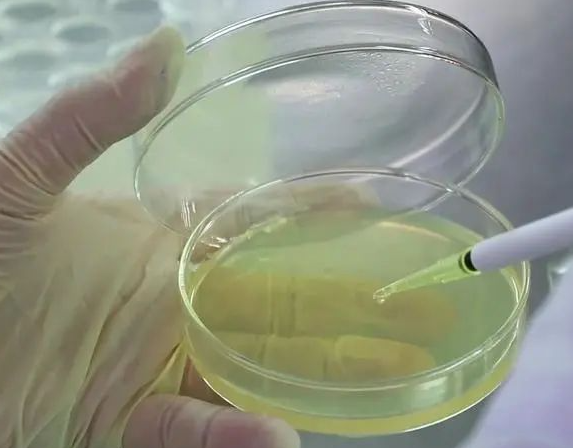

稀释涂布平板法详细介绍(原理及操作步骤)
发布时间:2024-09-27 浏览次数:12204
涂布平板法是一种常用的微生物学实验技术,主要用于分离、纯化和计数微生物。以下是该方法的详细介绍:
实验原理
涂布平板法的基本原理是通过将微生物悬液进行稀释,然后将稀释后的悬液均匀涂布在固体培养基表面。这样,微生物在培养基上生长时能够形成单个菌落,从而实现微生物的分离和纯化。
操作步骤
● 准备培养基:选择适当的固体培养基,如营养琼脂、胰蛋白胨大豆琼脂等,按照说明书或实验要求配制并灭菌。待培养基冷却至适宜温度后,倒入无菌平板中,使培养基在平板底部均匀铺展。

● 稀释微生物悬液:取一定量的微生物悬液,用无菌生理盐水或其他适当的稀释液进行逐步稀释。通常需要进行10倍系列稀释,以获得不同浓度的微生物悬液。
● 涂布平板:取适量稀释后的微生物悬液,用无菌玻璃刮刀或涂布器均匀涂布在固体培养基表面。涂布时要保持手法的稳定性和一致性,以确保微生物在培养基上分布均匀。
● 培养微生物:将涂布好的平板倒置放入恒温培养箱中,设置适当的温度和湿度条件进行培养。培养时间根据微生物的种类和生长特性而定,一般需要24~48小时。
注意事项
● 无菌操作:实验过程中要使用无菌器具和培养基,并在无菌工作台或超净工作台上进行操作,以避免微生物污染。
● 稀释倍数的选择:选择合适的稀释倍数是实现微生物分离和纯化的关键。稀释倍数过高可能导致微生物在培养基上无法形成菌落;稀释倍数过低则可能导致微生物在培养基上过度生长,形成菌落重叠。
● 涂布技巧:涂布时要保持手法的稳定性和一致性,涂布速度要适中,避免过快导致微生物分布不均或过慢导致培养基干燥。
结果分析
通过对涂布平板法得到的平板进行观察和计数,可以估算出原始微生物悬液中的微生物数量。观察平板上菌落的形态、大小和颜色等特征,可以初步判断微生物的种类和生长状态。
稀释涂布平板法计数微生物的计算公式
稀释涂布平板法是一种常用的微生物计数方法,通过对样品进行稀释并将稀释液均匀涂布于平板上,再根据平板上生长的菌落数量进行统计计算。在该方法中,每克样品中的菌株数可以通过以下公式计算得出:菌株数 = (C ÷ V) × M。
其中,C代表某一稀释度下平板上生长的平均菌落数,V代表涂布平板时所用稀释液的体积,M代表稀释倍数。通过这个公式,我们可以准确地根据实验结果计算出样品中微生物的数量,为微生物学研究和实验提供了重要的定量依据。
来源:环凯转载于“食品微生物检测”公众号,原作者~未知,内容版权归原作者所有;
说明:文章、视频、图片等所有内容,仅用于学习交流,若有侵权内容及其他涉法内容,请及时联系删除或修改,特此声明!
